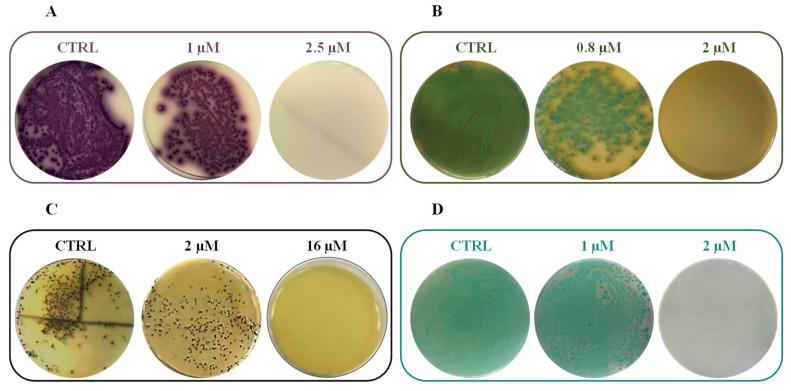
https://cdn.ncbi.nlm.nih.gov/pmc/blobs/301d/7555028/b17dc4a9ff7e/ijms-21-06952-g006.jpg

一种安全且多功能的抗菌十肽:从头设计到结构和功能表征的研究进展。
A Safe and Multitasking Antimicrobial Decapeptide: The Road from De Novo Design to Structural and Functional Characterization.
机构信息
Materias Srl, 80146 Naples, Italy.
Department of Food Microbiology, Istituto Zooprofilattico Sperimentale del Mezzogiorno, 80055 Portici, Italy.
出版信息
Int J Mol Sci. 2020 Sep 22;21(18):6952. doi: 10.3390/ijms21186952.
Antimicrobial peptides (AMPs) are excellent candidates to fight multi-resistant pathogens worldwide and are considered promising bio-preservatives to control microbial spoilage through food processing. To date, designing de novo AMPs with high therapeutic indexes, low-cost synthesis, high resistance, and bioavailability, remains a challenge. In this study, a novel decapeptide, named RiLK1, was rationally designed starting from the sequence of the previously characterized AMP 1018-K6, with the aim of developing short peptides, and promoting higher selectivity over mammalian cells, antibacterial activity, and structural resistance under different salt, pH, and temperature conditions. Interestingly, RiLK1 displayed a broad-spectrum of bactericidal activity against Gram-positive and Gram-negative bacteria, including multidrug resistant clinical isolates of species, with Minimal Bactericidal Concentration (MBC) values in low micromolar range, and it was effective even against two fungal pathogens with no evidence of cytotoxicity on human keratinocytes and fibroblasts. Moreover, RiLK1-activated polypropylene films were revealed to efficiently prevent the growth of microbial spoilage, possibly improving the shelf life of fresh food products. These results suggested that de novo designed peptide RiLK1 could be the first candidate for the development of a promising class of decameric and multitask antimicrobial agents to overcome drug-resistance phenomena.
抗菌肽 (AMPs) 是全球对抗多耐药病原体的优秀候选药物,被认为是通过食品加工控制微生物腐败的有前途的生物防腐剂。迄今为止,设计具有高治疗指数、低成本合成、高抗性和生物利用度的新型 AMP 仍然是一个挑战。在这项研究中,从先前表征的 AMP 1018-K6 的序列出发,合理设计了一种新型十肽,命名为 RiLK1,旨在开发短肽,并提高对哺乳动物细胞的更高选择性、抗菌活性和在不同盐、pH 和温度条件下的结构抗性。有趣的是,RiLK1 对革兰氏阳性和革兰氏阴性细菌表现出广谱杀菌活性,包括多药耐药临床分离株,其最小杀菌浓度 (MBC) 值处于低微摩尔范围内,即使对两种真菌病原体也有效,对人角质形成细胞和成纤维细胞没有细胞毒性证据。此外,已证明 RiLK1 激活的聚丙烯薄膜能够有效防止微生物腐败的生长,可能延长新鲜食品的保质期。这些结果表明,从头设计的肽 RiLK1 可能成为开发有前途的十肽和多任务抗菌剂类别的第一个候选药物,以克服耐药现象。